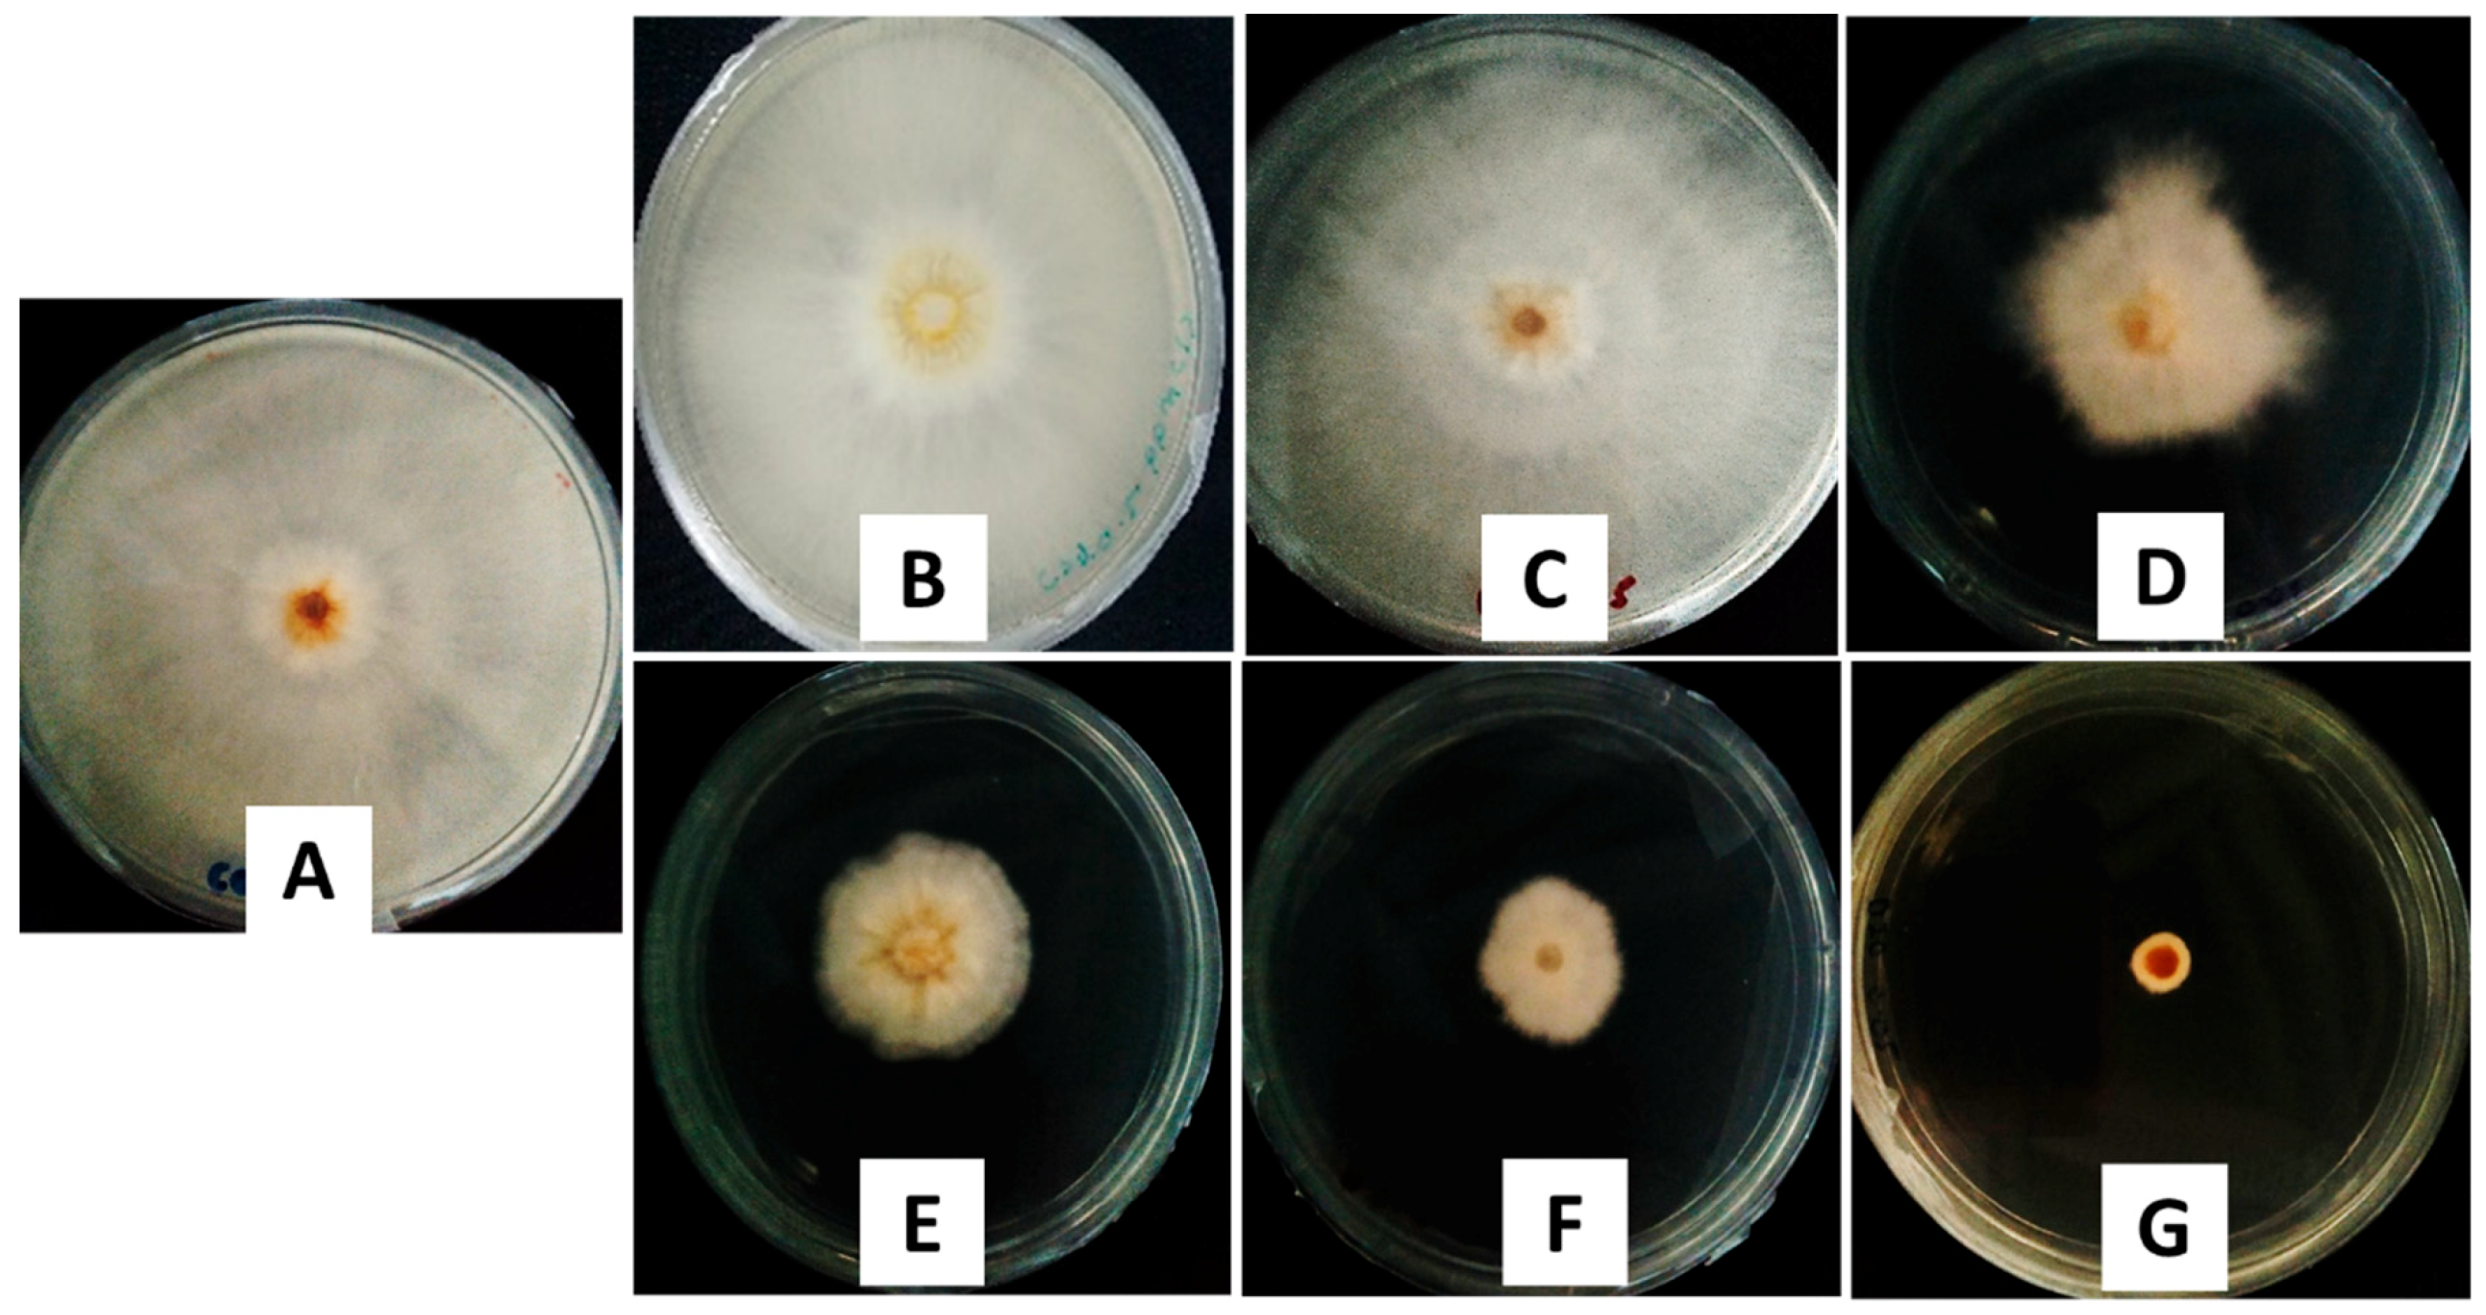
Ijms 20 02247 g007

A Potent Antifungal Agent for Basal Stem Rot Disease Treatment in Oil Palms Based on Chitosan-Dazomet Nanoparticles
Abstract
1. Introduction
2. Results and Discussions
2.1. Nanoparticle Characterizations
2.1.1. Reaction Yield and Dazomet Loading Encapsulation Efficiency
2.1.2. X-ray Diffraction
2.1.3. FTIR Spectroscopy
2.1.4. Thermal Analysis
2.1.5. Morphology and Particle Size Distribution
2.2. In Vitro Dazomet Release
2.3. Antifungal Efficacy on G. boninense
2.3.1. In Vitro Antifungal Activity Assay
2.3.2. Mathematical Modeling of Fungal Growth
3. Materials and Methods
3.1. Materials
3.2. Preparation of Chitosan-Dazomet Nanoparticles
3.3. Reaction Yield and Dazomet Loading Encapsulation Efficiency
3.4. Dazomet Release Profile Study
3.5. Characterizations
3.6. In Vitro Antifungal Activity Studies
3.7. Statistical Analysis
4. Conclusions
Author Contributions
Funding
Acknowledgments
Conflicts of Interest
References
- Vijaya, S.; Mrudula, T.; Naga Deepth, C.; Sree, V. Novel applications of nanotechnology in life sciences. J. Bioanal. Biomed. 2011, S11, 1–4. [Google Scholar]
- Kalpana, S.; Rashmi, H.B.; Rao, N.H. Nanotechnology patents as R&D indicators for disease management strategies in agriculture. J. Intellect. Prop. Rights 2010, 15, 197–205. [Google Scholar]
- Gogos, A.; Knauer, K.; Bucheli, T.D. Nanomaterials in plant protection and fertilization: Current state, foreseen applications, and research priorities. J. Agri. Food Chem. 2012, 60, 9781–9792. [Google Scholar] [CrossRef] [PubMed]
- Chinnamuthu, C.; Boopathi, P.M. Nanotechnology, and agroecosystem. Madras Agric. J. 2009, 96, 17–31. [Google Scholar]
- Mukhopadhyay, S.S. Nanotechnology in agriculture: Prospects and constraints. Nanotechnol. Sci. Appl. 2014, 7, 63. [Google Scholar] [CrossRef] [PubMed]
- Parisi, C.; Vigani, M.; Rodríguez-Cerezo, E. Agricultural nanotechnologies: What are the current possibilities? Nano Today 2015, 10, 124–127. [Google Scholar] [CrossRef]
- Ho, Y.W.; Nawawi, A. Ganoderma boninense Pat. from basal stem rot of oil palm (Elaeis guineensis) in Peninsular Malaysia. Pertanika 1985, 8, 425–428. [Google Scholar]
- Susanto, A.; Sudharto, P.; Purba, R. Enhancing biological control of basal stem rot disease (Ganoderma boninense) in oil palm plantations. Mycopathologia 2005, 159, 153–157. [Google Scholar] [CrossRef]
- Siddiquee, S.; Yusuf, U.K.; Hossain, K.; Jahan, S. In vitro studies on the potential Trichoderma harzianum for antagonistic properties against Ganoderma boninense. J. Food Agric. Env. 2009, 7, 970–976. [Google Scholar]
- Bivi, M.R.; Farhana, M.; Khairulmazmi, A.; Idris, A. Control of Ganoderma boninense: A causal agent of basal stem rot disease in oil palm with endophyte bacteria in vitro. Int. J. Agric. Biol. 2010, 12, 833–839. [Google Scholar]
- Ariffin, D.; Idris, A.; Singh, G. Status of Ganoderma in oil palm. Ganoderma Dis. Perenn. Crop. 2000, 1, 49–68. [Google Scholar] [CrossRef]
- Taylor, F.I.; Kenyon, D.; Rosser, S. Isothiocyanates inhibit fungal pathogens of potato in in vitro assays. Plant Soil 2014, 382, 281–289. [Google Scholar] [CrossRef]
- Idris, A.; Maizatul, S. Stump treatment with dazomet for controlling Ganoderma disease in oil palm. MPOB. TS Inf. Ser. 2012, 107, 615–616. [Google Scholar]
- Sebti, I.; Martial-Gros, A.; Carnet-Pantiez, A.; Grelier, S.; Coma, V. Chitosan polymer as bioactive coating and film against Aspergillus niger contamination. J. Food Sci. 2005, 70, M100–M104. [Google Scholar] [CrossRef]
- López-Mora, L.; Gutiérrez-Martínez, P.; Bautista-Baños, S.; Jiménez-García, L.; Zavaleta-Mancera, H. Evaluation of antifungal activity of chitosan in Alternaria alternata and in the quality of’ Tommy Atkins’ mango during storage. Rev. Chapingo. Ser. Hortic. 2013, 19, 315–331. [Google Scholar] [CrossRef]
- Jeihanipour, A.; Karimi, K.; Taherzadeh, M.J. Antimicrobial properties of fungal chitosan. Int. Res. J. Biol. Sci. 2007, 2, 239–243. [Google Scholar]
- Goy, R.C.; Britto, D.D.; Assis, O.B. A review of the antimicrobial activity of chitosan. Polímeros 2009, 19, 241–247. [Google Scholar] [CrossRef]
- Guerra-Sanchez, M.G.; Vega-Pérez, J.; Velazquez-Del Valle, M.G.; Hernandez-Lauzardo, A.N. Antifungal activity and release of compounds on Rhizopus stolonifer (Ehrenb.: Fr.) Vuill. by effect of chitosan with different molecular weights. Pestic. Biochem. Physiol. 2009, 93, 18–22. [Google Scholar] [CrossRef]
- Vinsova, J.; Vavrikova, E. Chitosan derivatives with antimicrobial, antitumour and antioxidant activities-a review. Curr. Pharm. Des. 2011, 17, 3596–3607. [Google Scholar] [CrossRef]
- Fan, W.; Yan, W.; Xu, Z.; Ni, H. Formation mechanism of monodisperse, low molecular weight chitosan nanoparticles by ionic gelation technique. Colloids. Surf. B Biointerfaces 2012, 90, 21–27. [Google Scholar] [CrossRef] [PubMed]
- Hu, B.; Pan, C.; Sun, Y.; Hou, Z.; Ye, H.; Hu, B.; Zeng, X. Optimization of fabrication parameters to produce chitosan−tripolyphosphate nanoparticles for delivery of tea catechins. J. Agri. Food Chem. 2008, 56, 7451–7458. [Google Scholar] [CrossRef]
- Shi, Y.; Wan, A.; Shi, Y.; Zhang, Y.; Chen, Y. Experimental and mathematical studies on the drug release properties of aspirin loaded chitosan nanoparticles. Biomed. Res. Int. 2014. [Google Scholar] [CrossRef] [PubMed]
- Sharma, N.; Madan, P.; Lin, S. Effect of process and formulation variables on the preparation of parenteral paclitaxel-loaded biodegradable polymeric nanoparticles: A co-surfactant study. Asian J. Pharma. Sci. 2016, 11, 404–416. [Google Scholar] [CrossRef]
- Chen, W.; Palazzo, A.; Hennink, W.E.; Kok, R.J. Effect of particle size on drug loading and release kinetics of gefitinib-loaded PLGA microspheres. Mol. Pharm. 2016, 14, 459–467. [Google Scholar] [CrossRef]
- Hussein-Al-Ali, S.H.; Kura, A.; Hussein, M.Z.; Fakurazi, S. Preparation of chitosan nanoparticles as a drug delivery system for perindopril erbumine. Polym. Compos. 2018, 39, 544–552. [Google Scholar] [CrossRef]
- Mohan, S.; Sundaraganesan, N.; Mink, J. FTIR and Raman studies on benzimidazole. Spectrochim. Acta A 1991, 47, 1111–1115. [Google Scholar] [CrossRef]
- Mustafa, I.F.; Hussein, M.Z.; Seman, I.A.; Hilmi, N.H.Z.; Fakurazi, S. Synthesis of dazomet-zinc/aluminum-layered double hydroxide nanocomposite and its phytotoxicity effect on oil palm seed growth. Acs. Sustain. Chemi. Eng. 2018, 6, 16064–16072. [Google Scholar] [CrossRef]
- Ho, Y.; McKay, G. A comparison of chemisorption kinetic models applied to pollutant removal on various sorbents. Process. Saf. Env. 1998, 76, 332–340. [Google Scholar] [CrossRef]
- Tan, J.M.; Karthivashan, G.; Gani, S.A.; Fakurazi, S.; Hussein, M.Z. Biocompatible polymers coated on carboxylated nanotubes functionalized with betulinic acid for effective drug delivery. J. Mater. Sci. Mater. Med. 2016, 27, 26. [Google Scholar] [CrossRef]
- Yien, L.; Zin, N.M.; Sarwar, A.; Katas, H. Antifungal activity of chitosan nanoparticles and correlation with their physical properties. Int. J. Biomater. 2012. [Google Scholar] [CrossRef]
- Mohamed, R.R.; Sabaa, M.W. Synthesis and characterization of antimicrobial crosslinked carboxymethyl chitosan nanoparticles loaded with silver. Int. J. Biol. Macro. 2014, 69, 95–99. [Google Scholar] [CrossRef] [PubMed]
- Nguyen, T.T.T.; Tae, B.; Park, J.S. Synthesis and characterization of nanofiber webs of chitosan/poly (vinyl alcohol) blends incorporated with silver nanoparticles. J. Mater. Sci. 2011, 46, 6528–6537. [Google Scholar] [CrossRef]
- Raimondi, F.; Scherer, G.G.; Kötz, R.; Wokaun, A. Nanoparticles in energy technology: Examples from electrochemistry and catalysis. Angew. Chem. Int. Ed. 2005, 44, 2190–2209. [Google Scholar] [CrossRef] [PubMed]
- Halmi, M.I.E. Evaluation of several mathematical models for fitting the growth and kinetics of the catechol-degrading candida parapsilopsis: Part 1. J. Env. Bioremed. Toxic. 2014, 2, 48–52. [Google Scholar]
- Othman, A.R.; Johari, W.L.W.; Dahalan, F.A.; Shukor, M.Y. Mathematical modeling of molybdenum blue production from Serratia marcescens strain DR. Y10. Bioremed. Sci. Tech. Res. 2015, 3, 1–6. [Google Scholar]
- Khaira, R.; Sharma, J.; Saini, V. Development and characterization of nanoparticles for the delivery of gemcitabine hydrochloride. Sci. World J. 2014. [Google Scholar] [CrossRef] [PubMed]

| Synthesized Nanoparticles | Reaction Yield * (%) | Loading Content * (%) | Encapsulation Efficiency * (%) |
|---|---|---|---|
| CDEN2.5 | 60.5 ± 2.5a | 28.3 ± 3.5a | 78.3 ± 5.0a |
| CDEN5 | 76.0 ± 3.0b | 47.8 ± 2.0b | 97.8 ± 2.5b |
| CDEN10 | 73.3 ± 2.0b | 34.8 ± 4.0c | 84.8 ± 3.0c |
| CDEN20 | 75.0 ± 3.5b | 33.2 ± 2.0c | 83.2 ± 4.5c |
| Parameters | Type of Fumigants | |||||
|---|---|---|---|---|---|---|
| Chitosan | Pure Dazomet | CDEN2.5 | CDEN5 | CDEN10 | CDEN20 | |
| EC50 (ppb) | 1534.5 | 152.2 | 25.4 | 20.7 | 14.5 | 4.6 |
| Fiducial limit (ppb)(lower–upper) | 494.0–13280.4 | 73.2–565.8 | 12.8–63.6 | 8.5–76.0 | 7.2–38.6 | 3.4–6.6 |
| Parameters | Type of Fumigants | |||||
|---|---|---|---|---|---|---|
| Chitosan | Pure Dazomet | CDEN2.5 | CDEN5 | CDEN10 | CDEN20 | |
| A * | 57.75 ± 10.84a | 64.79 ± 14.34a | 38.21 ± 2.59b | 40.53 ± 5.16b | 34.90 ± 1.54b | 24.65 ± 7.57c |
| μmax * (day −1) | 45.90 ± 0.32a | 43.51 ± 0.19a | 32.41 ± 0.21b | 32.33 ± 0.27b | 27.48 ± 0.10c | 17.86 ± 0.20d |
| λ * (day) | 1.46 ± 0.11a | 1.36 ± 0.08b | 1.57 ± 0.07a | 1.50 ± 0.09a | 1.50 ± 0.03a | 1.34 ± 0.09b |
| R2 | 0.992 | 0.994 | 0.997 | 0.995 | 0.999 | 0.994 |
© 2019 by the authors. Licensee MDPI, Basel, Switzerland. This article is an open access article distributed under the terms and conditions of the Creative Commons Attribution (CC BY) license (http://creativecommons.org/licenses/by/4.0/).
Share and Cite
Maluin, F.N.; Hussein, M.Z.; Yusof, N.A.; Fakurazi, S.; Idris, A.S.; Hilmi, N.H.Z.; Jeffery Daim, L.D. A Potent Antifungal Agent for Basal Stem Rot Disease Treatment in Oil Palms Based on Chitosan-Dazomet Nanoparticles. Int. J. Mol. Sci. 2019, 20, 2247. https://doi.org/10.3390/ijms20092247
Maluin FN, Hussein MZ, Yusof NA, Fakurazi S, Idris AS, Hilmi NHZ, Jeffery Daim LD. A Potent Antifungal Agent for Basal Stem Rot Disease Treatment in Oil Palms Based on Chitosan-Dazomet Nanoparticles. International Journal of Molecular Sciences. 2019; 20(9):2247. https://doi.org/10.3390/ijms20092247
Chicago/Turabian StyleMaluin, Farhatun Najat, Mohd Zobir Hussein, Nor Azah Yusof, Sharida Fakurazi, Abu Seman Idris, Nur Hailini Zainol Hilmi, and Leona Daniela Jeffery Daim. 2019. "A Potent Antifungal Agent for Basal Stem Rot Disease Treatment in Oil Palms Based on Chitosan-Dazomet Nanoparticles" International Journal of Molecular Sciences 20, no. 9: 2247. https://doi.org/10.3390/ijms20092247
APA StyleMaluin, F. N., Hussein, M. Z., Yusof, N. A., Fakurazi, S., Idris, A. S., Hilmi, N. H. Z., & Jeffery Daim, L. D. (2019). A Potent Antifungal Agent for Basal Stem Rot Disease Treatment in Oil Palms Based on Chitosan-Dazomet Nanoparticles. International Journal of Molecular Sciences, 20(9), 2247. https://doi.org/10.3390/ijms20092247

